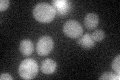
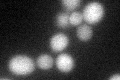
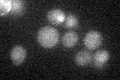

View description
Apparent pseudogene, not transcribed or translated under normal conditions; encodes a protein with similarity to adenine phosphoribosyltransferase, but artificially expressed protein exhibits no enzymatic activity
Localization:
Intensity:
Fold change:
Significance:
-
C’ GFP library in SD
cytosol30.22 -
N' NOP1pr-GFP in SD

N/A0 -
N' TEF2pr-mCherry in SD

N/A0 -
N' NATIVEpr-GFP in SD

N/A0 -
N' TEF2pr-VC and Cyto-VN in SD

N/A0 -
C’ GFP library in SD+DTT
cytosol23.480.77No -
C’ GFP library in SD+H2O2

cytosol27.010.89No -
C’ GFP library in Starvation Media
cytosol29.550.97No -
C’ GFP library on the background of Pup2-DaMP

cytosol -
C’ GFP library on the background of CCT mutant

cytosol27.73310.917593No
